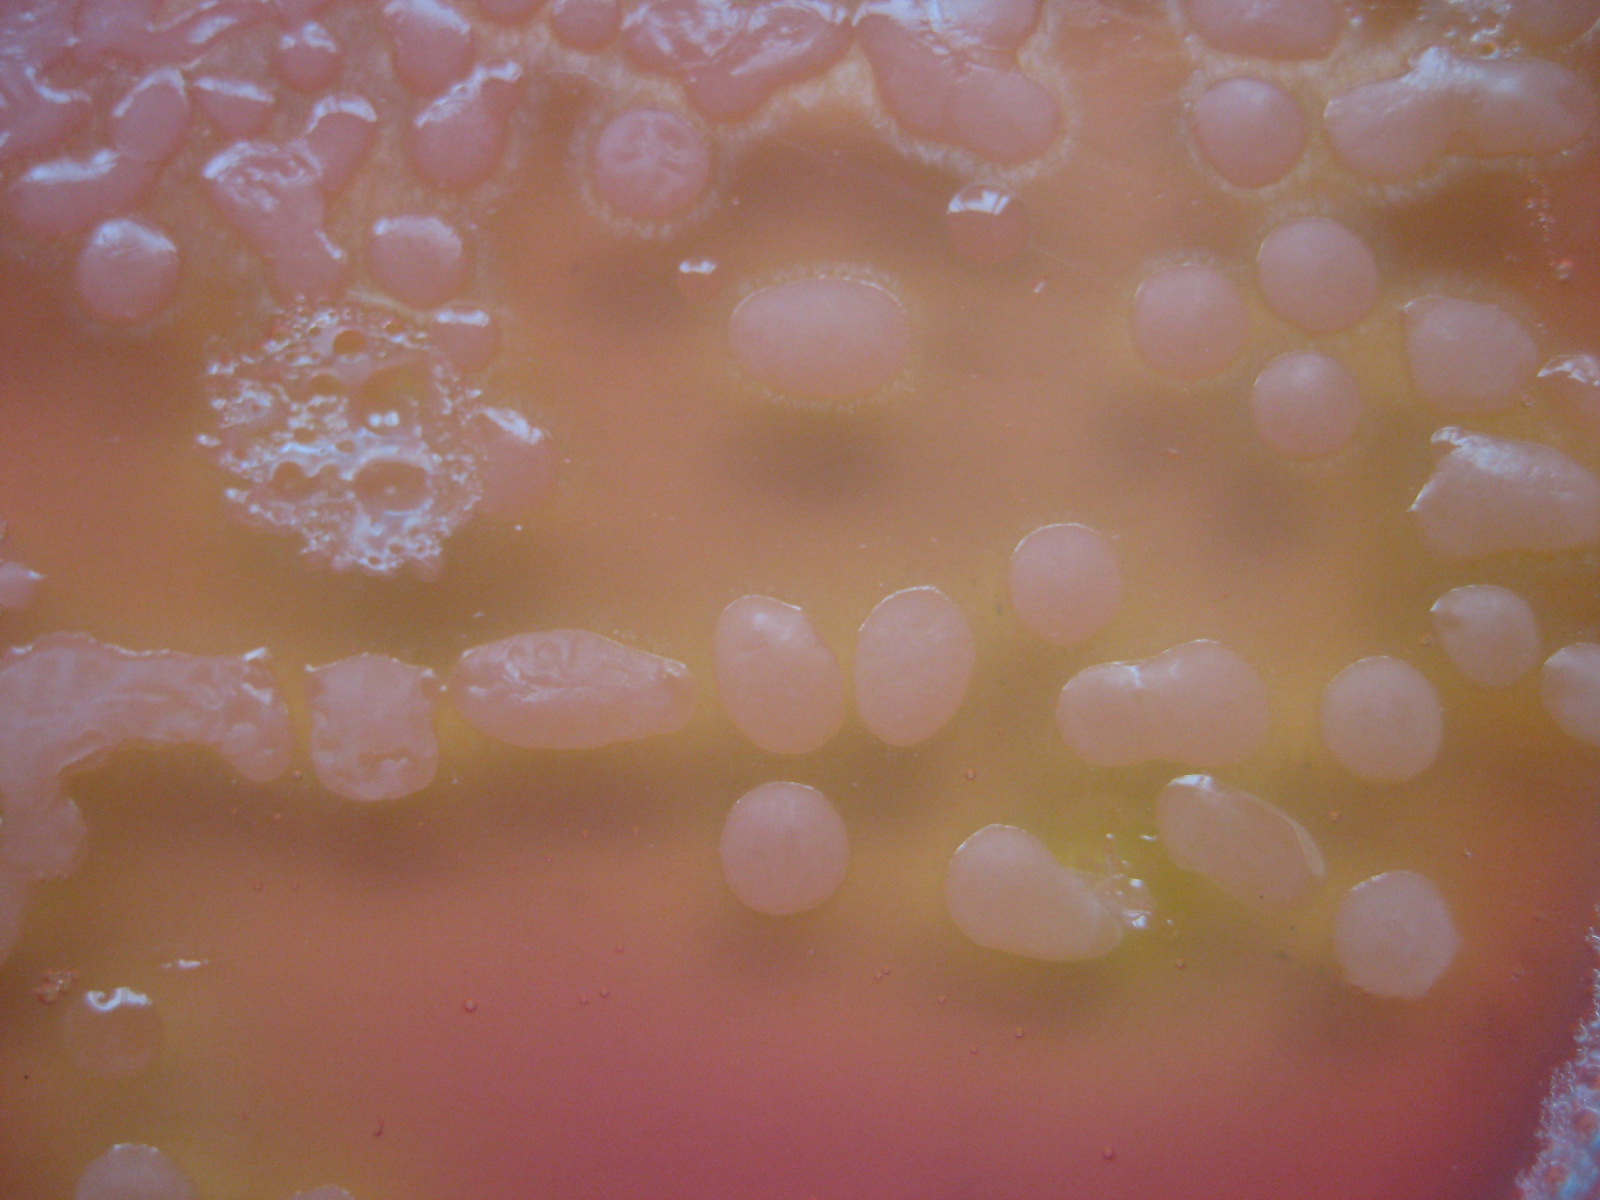
蜡状芽孢杆菌蕈状变种

蜡样芽孢杆菌

蜡样芽胞杆菌
图片尺寸2896x5152
蜡样芽胞杆菌
图片尺寸5152x2896
蜡状芽胞杆菌群是一类广泛分布于不同环境中的细菌,具有丰富多样的
图片尺寸2136x1280
蜡样芽孢杆菌片的介绍
图片尺寸450x299
微生物.忽然觉得微生物好像也挺好玩的,今日份的蜡样芽孢杆菌# - 抖音
图片尺寸1440x1458
蜡样芽胞杆菌
图片尺寸2896x5152
蜡状芽孢杆菌
图片尺寸859x966
蜡样芽孢杆菌 油镜下,100倍
图片尺寸1052x1280
蜡样芽孢杆菌活菌胶囊 0.25g*20粒 1盒【多盒更划算】
图片尺寸500x500
蜡样芽孢杆菌
图片尺寸392x328蜡样芽孢杆菌
图片尺寸1080x1080
蜡样芽孢杆菌
图片尺寸600x372一日一菌蜡样芽孢杆菌
图片尺寸1080x810
蜡样芽胞杆菌
图片尺寸2896x5152
蜡状芽孢杆菌
图片尺寸268x278
蜡样芽孢杆菌
图片尺寸600x372
的细菌有许多种,但以沙门氏菌,志贺氏菌,葡萄球菌,蜡样芽孢杆菌等多见
图片尺寸900x676
兼性厌氧型的"仙人掌杆菌"——蜡样芽孢杆菌
图片尺寸800x603
一株蜡样芽孢杆菌及其应用
图片尺寸689x1000蜡状芽孢杆菌蕈状变种
图片尺寸1600x1200
猜你喜欢:蜡样芽孢杆菌MYP短小芽孢杆菌蜡样芽孢杆菌菌落图片蜡样芽孢杆菌镜检蕈状芽孢杆菌蜡样芽孢杆菌活菌片蜡样芽孢杆菌图片蜡样芽孢杆菌活菌胶囊炭疽芽孢杆菌蜡样芽孢杆菌革兰染色蜡样芽孢杆菌镜检图片芽孢杆菌菌落巨大芽孢杆菌地衣芽孢杆菌蜡样芽孢杆菌血平板蜡样芽孢杆菌菌落蜡样芽孢杆菌显微镜图蜡状芽孢杆菌蜡样芽孢杆菌片芽孢杆菌凝结芽孢杆菌芽孢杆菌图片贝莱斯芽孢杆菌凝结芽孢杆菌活菌片纳豆芽孢杆菌苏云金芽孢杆菌多粘类芽孢杆菌地衣芽孢杆菌活菌颗粒地衣芽孢杆菌活菌胶囊解淀粉芽孢杆菌鹿跪坐假面骑士build满瓶图鉴重症腐蹄口蹄血清售价重庆警备区政委高步明鸣人的假期无白屏版遭人算计的图片我有情绪我想闹人图片外卖餐盒小懒猫睡觉图片美容背景图片大全图林志玲加油哦飞利浦吸尘器拆机图解